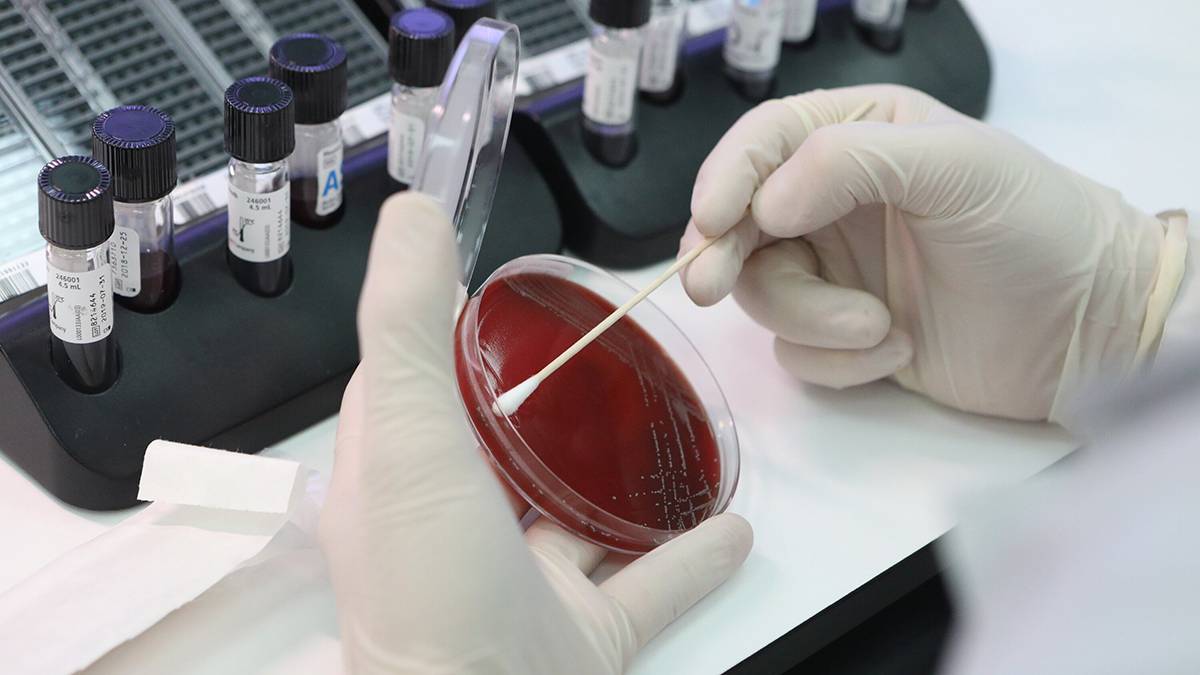
Ученые раскрыли истинное происхождение COVID-19

Две мутации более 400 миллионов лет назад вызвали появление сложного железосодержащего белка. Международная команда исследователей во главе с профессором Чикагского университета Джозефом Торнтоном, доктором наук и аспирантом Арвиндо.
Опубликовано: 16:14, января 9, 2026 в: «Наука»; Сообщает источник: versiya.info; Поделитесь новостью:

Ученые раскрыли истинное происхождение COVID-19
Группа ученых провела исследование и установила, что коронавирус COVID-19 сформировался естественным путем на рынке в китайском Ухане. …

Ученые раскрыли происхождение загадочных вспышек в космосе
В марте 2021 года астрономы наблюдали высокоэнергетический всплеск света из далекой галактики. Присвоив явлению название AT 2021hdr, его посчитали св …

Учёные выяснили, как именно стареют люди
Недавние исследования в области геномики и персонализированной медицины дают новый взгляд на понимание процессов старения. Оказывается, оно отличаетс …

Ученые выяснили, как работает эффект плацебо
Недавние опыты, проведенные на мышах, выявили почему плацебо или медицинские вмешательства без терапевтического действия могут облегчать боль. Это св …

Учёные выяснили неожиданный факт об аутизме
Учёные выяснили, что аутизм берет свое начало задолго до появления ребёнка на свет, а не в процессе социализации, как считалось ранее. Проблема кроет …

Учёные выяснили, как благодарность улучшает здоровье
Выражение благодарности, как показало новое исследование, проведённое Кристофером Овейсом, доцентом Школы менеджмента Рэди Калифорнийского университе …

Мухам нравится кататься на каруселях, выяснили ученые
Международная группа ученых из Лейпцигского университета (Германия) и Нортумбрийского университета (Великобритания) выяснила, что плодовые мушки (Dro …

Жара ускорила старение комаров, выяснили ученые
Американские ученые из Вандербильтского университета выяснили, что повышение глобальных температур ускоряет старение комаров, а также ухудшает их имм …

Люди и животные: учёные выяснили, чья культура сложнее
Ученые знают, не только люди умеют создавать сложную культуру — животные тоже на это способны. Культура — это когда знания, привычки или умения перед …

Ученые выяснили, почему ночью так хочется есть
Исследование среди молодежи показало тесную взаимосвязь между пищевыми привычками и циркадными ритмами. Подростки, страдающие ожирением и избыточным …

Ученые выяснили, как рак желудка становится независимым от тканей
Международная группа ученых выявила ранее неизвестный механизм, который позволяет клеткам рака желудка на ранних стадиях выживать и расти без поддерж …

Учёные выяснили, что физиотерапия помогает при головных болях
Существует большое количество исследований, показывающих, что физиотерапевтические процедуры могут быть полезны при определённых типах головной боли. …

Учёные изучали людей с собаками десятилетиями — вот что они выяснили
Собаки и психическое здоровье: питомцы лечат стресс и депрессию лучше таблеток. Учёные ни одно десятилетие изучают влияние собак на психическое здоро …

Учёные выяснили, как вернуть забытые воспоминания из детства
Эксперты из Университета Англия Раскин нашли способ помочь человеку вспомнить события своих ранних лет. Главную роль в этом играет то, как наш мозг в …

Мантия Земли расколота надвое, выяснили ученые
Австралийские ученые из Кертинского университета совместно с китайскими коллегами из лаборатории Лаошань в Циндао пришли к выводу, что мантия Земли р …

Ученые выяснили, как музыка влияет на человеческий мозг
Группа ученых под руководством Эдварда Ларджа из Университета Коннектикута выяснила, что человеческий мозг не просто обрабатывает музыка, а синхрониз …

Кастрация и стерилизация продлевают жизнь, выяснили ученые
Ученые Университета Отаго установили, что подавление репродуктивной функции увеличивает продолжительность жизни у самцов и самок множества видов в ср …

Ученые выяснили, что ругательства повышают выносливость при нагрузках
Британские исследователи пришли к выводу, что использование нецензурной лексики может повышать физическую выносливость во время интенсивных упражнени …

Медитация и растяжка помогают при циррозе, выяснили ученые
Ученые Мичиганского университета обнаружили, что растяжка и медитация выступают эффективными способами облегчения ночных мышечных спазмов у пациентов …

Транспортный шум разрушает здоровье сердца, выяснили ученые
Воздействие транспортного шума (автомобильного и авиационного) связано с повышенным риском мерцательной аритмии (фибрилляция предсердий). Это показал …

Учёные выяснили, что без сна человекообразные роботы утрачивают эффективность
Оказалось, даже нейросети нужен отдых. Учёные из американской Лос-Аламосской национальной лаборатории обнаружили, что без сна человекообразные роботы …

Учёные выяснили, что общение с телефоном портит настроение
Ученые изучили цифровое поведение почти 10 тысяч человек. Оказалось, что раздражение и плохое настроение зависят не от устройства и даже не от времен …

Ученые выяснили, какие яблоки самые полезные
Ученые из Грацского технического университета (Австрия) установили, что в органических яблоках больше полезных бактерий, чем в традиционно выращенных …

Ученые выяснили, что кожные клещи очищают кожу
Ученые из университетов Рединга и Бангора впервые расшифровали геном кожных клещей Demodex folliculorum и выяснили, что они приносят пользу, помогая …

Горькое соединение в шоколаде замедляет старение, выяснили ученые Ученые из Королевского колледжа Лондона обнаружили, что теобромин — природное соединение, придающее темному шоколаду горький вкус — может замедлять с …

Ученые выяснили, что тираннозавры могли быть на 70% больше, чем предполагалось Ученые Канадского музея природы в Оттаве и Лондонского университета королевы Марии провели исследование, которое помогло смоделировать максимально во …

Разговоры за рулем замедляют движения глаз, выяснили ученые Ученые из Университета здравоохранения Фудзиты установили, что разговор за рулем создает когнитивную нагрузку, достаточную для замедления движений гл …

Учёные выяснили, какие области мозга отвечают за любовь Более полное изображение мозга помогло экспертам понять, почему мы используем слово «любовь» для описания такого большого количества переживаний. Рез …

Ученые выяснили, что только 0,1 % челябинского метеорита достигла Земли Уральские ученые узнали, что челябинский метеорит потерял до 99,9 % своего объема, когда вошел в атмосферу Земли. …

Жир на животе повышает риск развития деменции, выяснили ученые Ученые из Сычуаньского университета в Китае установили, что накопление жира по абдоминальному типу (в области живота) и на руках повышает риск развит …

Зависимость от смартфона — не про дофамин: учёные выяснили настоящую причину Мы тянемся к смартфону не ради лайков, и наука наконец это доказала. Мы привыкли думать, что люди залипают в смартфонах из-за лайков, уведомлений и б …

Ученые выяснили, что образованные люди долго остаются одни Высшее образование может быть фактором, продлевающим одиночество в молодости. К такому выводу пришли учёные из Цюриха, проводившие масштабное исследо …

«Кровь» устриц может бороться с супербактериями, выяснили ученые Ученые из Университета Южного Креста в Австралии установили, что белки, обнаруживаемые в гемолимфе сиднейской каменной устрицы (Saccostrea glomerata) …

Ученые выяснили, когда рак груди может метастазировать в мозг Ученые Тель-Авивского университета установили, что высокая активность фермента SCD1 в опухолевых клетках ведет к метастазированию рака молочной желез …

Смартфоны могут усиливать боль от одиночества, выяснили ученые Ученые из Университетской клиники Гейдельберга установили, что чрезмерное использование смартфонов связано с усиленной "социальной болью" — усиленной …

Ученые выяснили причину массовой гибели слонов в Ботсване Британские и ботсванские экологи обнаружили, что массовая гибель слонов в 2020 году в Ботсване была связана с тем, что засухи и последовавшие за ними …

Ученые выяснили, как раннее приучение к смартфону влияет на детей Исследователи впервые установили связь между экранным временем в младенчестве и изменениями в работе мозга. …

Ученые выяснили, как опасный моллюск распространяется по водоемам России Ученые Федерального исследовательского центра комплексного изучения Арктики имени академика Лаверова Уральского отделения РАН (ФИЦКИА, Архангельск) в …

Ученые выяснили, как обнаружить комету до того, как она упадет на Землю Исследователи из Северо-Аризонского университета разработали метод, позволяющий обнаружить кометы, которые не приближались к Земле более 200 лет. Осн …

Ставропольские ученые выяснили последствия смещения режима сна у студентов Международная группа ученых с участием специалистов Северо-Кавказского федерального университета изучила последствия изменения режима сна в будни и в …

Ученые выяснили, как именно Марс стал непригодным для жизни Американские ученые из Национального управления по аэронавтике и исследованию космического пространства (NASA) получили новые данные, показывающие, к …

Ученые выяснили, сколько лет осталось существовать жизни на Земле Учёные из Чикагского университета под руководством Р. Дж. Грэма предупреждают о серьезных изменениях на Земле, которые произойдут через один миллиард …

Учёные выяснили, как онлайн-учёба сказывается на здоровье детей Во времена пандемии многих перевели на дистанционное обучение или работу. Студенты сдавали экзамены по видеосвязи в Zoom, айтишники, бухгалтеры и дру …

Учёные выяснили, какую пищу ели первые люди на Земле Команда учёных в ходе нового исследования обнаружила новые подробности о связи между человеком и бактериями в его желудке. Опубликованы были все данн …

Ученые выяснили, что мозг человека делит день на "главы" Ученые из Колумбийского университета обнаружили, что значимая смена деятельности человека в течение дня вызывает большой сдвиг в мозговой активности. …

Учёные выяснили, каким образом микробы едят железо Новое исследование, проведенное учеными из Университета Южной Дании, раскрыло, как микробы разрушают железные конструкции в бескислородных средах, пр …

Бергамот может защищать от ожирения печени, выяснили ученые Полифенолы бергамота могут снижать жировую инфильтрацию печени и улучшать метаболические показатели органа при уже развившемся стеатозе. К таким выво …

Ученые выяснили, как образовался гигантский аметист редкого цвета Пятиметровые аметистовые жеоды из северного Уругвая известны во всем мире. Но геологи только сейчас выяснили, при каких условиях образовались эти уни …

Учёные выяснили, недостаток какого витамина вызывает старость Польские учёные обнаружили, что дефицит витамина D3 может повлиять на здоровье мозга, способствуя развитию болезней Альцгеймера, Паркинсона и рассеян …

Ученые выяснили, почему люди ходят так, а не иначе, и как это все координируется в мозге Исследование Университета Осаки показывает, что мозг эффективно управляет координацией при ходьбе, вмешиваясь только при значительном смещении ног, ч …

Ученые выяснили, как развивались магматические океаны на ранней Земле и Марсе До того как Земля стала известна как "голубая планета", её поверхность была покрыта гигантским океаном магмы, простирающимся на сотни или даже тысячи …

Ученые выяснили, насколько сильно алкоголь влияет на когнитивные функции Новейшие исследования, проведенные на крысах в Университете Джонса Хопкинса, продемонстрировали, насколько существенно алкоголь может ухудшить когнит …

Хот-дог отнимает 36 минут жизни! Какие ещё продукты нас убивают, выяснили учёные Учёные из Мичиганского университета определили, что хот-дог сокращает жизнь в среднем на 36 минут, а если запить его газировкой, отнимите ещё 12 мину …

Вода из кулеров может быть грязнее водопроводной, выяснили ученые Ученые из Университета Лома-Линда выяснили, что вода в коммерческих автоматах и кулерах в общественных местах может содержать больше микробов, чем об …

Белковая диета защищает от опасной кишечной инфекции, выяснили ученые Ученые из Калифорнийского университета в Риверсайде показали, что диета с высоким содержанием определенных белков может резко снижать способность воз …

Любовь по словарю: ученые выяснили как лексикон влияет на выбор партнера Количество слов, которое человек знает, понимает и активно использует, может оказывать влияние на выбор романтического партнера. К такому выводу приш …

COVID-19 меняет микроструктуру мозга после выздоровления, выяснили ученые COVID-19 меняет микроструктуру двух областей мозга даже после выздоровления. К такому выводу пришли ученые из Университета Гриффита. Результаты опубл …

Расходы из-за глобального потепления выросли почти в шесть раз, выяснили ученые Американские ученые из Северо-Западного университета в Чикаго пришли к выводу, что расходы человечества из-за глобального потепления оказались в шест …

Американские ученые выяснили, как убивали мамонтов копьями древние люди Лос-Анджелес. США. Стало известно, как древние люди использовали копья в охоте на мамонтов. Способ убийства огромных животных установили археологи из …

Пестициды повышают риск нескольких типов рака, выяснили ученые Ученые из Университета Роки Виста (США) сравнили риск развития рака из-за использования сельскохозяйственных пестицидов с курением. Результаты исслед …

Ученые выяснили, как мозг реагирует на шесть разных видов любви Недавнее исследование, опубликованное в журнале Cerebral Cortex, расширило представления о том, как мозг реагирует на шесть различных типов любви. С …

Ученые выяснили, чем занималась в последние минуты жизни жительница Помпей В Помпеях нашли дом, хозяйка которого пыталась достать свои сбережения из сундука в последние минуты жизни во время извержения Везувия. Об этом сообщ …

Древний тектонический импульс перекроил эволюцию человека, выяснили ученые Международная группа ученых из Норвегии, Италии, Германии и США обнаружила, что подъем Аравийского полуострова 20 млн лет назад, вызванный глубинными …

Ученые выяснили, у каких людей больше шансов на здоровое старение Ученые из Гарвардской медицинской школы установили, что только один человек из десяти стареет благополучно. При этом женщины имеют на 29% больше шанс …

Уничтоживший динозавров астероид ускорил эволюцию птиц, выяснили ученые Международная группа ученых из США, Великобритании и Канады нашла связь между массовым вымиранием конца мелового периода 66 млн лет назад и стартом б …

Создание лесов в Арктике может ускорить ее таяние, выяснили ученые Датские ученые из Орхусского университета пришли к выводу, что создание новых лесов на арктических территориях способно ускорить изменение климата во …

Эмодзи действительно помогают строить близкие отношения, выяснили учёные Использование эмодзи в переписке может улучшить отношения между людьми, показало исследование, опубликованное в журнале PLOS One. Учёные из Университ …

Привычный напиток повышает плотность костей у женщин, выяснили ученые Регулярное употребление чая коррелирует с более высокой плотностью костей у пожилых женщин. К такому выводу пришли ученые из Университета Флиндерса ( …

История с неприятным запахом: учёные выяснили, что сделало человека человеком Мы привыкли считать, что путь человека к вершине пищевой цепи начался с охоты. Однако новое исследование испанских учёных показывает: в ранней истори …

Бамбук может снижать уровень сахара в крови, выяснили ученые Ученые из Университета Англия Раскин установили, что употребление побегов бамбука улучшает контроль уровня сахара в крови, снижает воспаление и подде …

Болезнь Альцгеймера наносит удар по мозгу в два этапа, выяснили ученые Новое исследование, основанное на современных методах картирования мозга, показывает, что болезнь Альцгеймера вызывает повреждения в два этапа. На пе …

Учёные выяснили, что климатические изменения влияют на время трансатлантических перелётов Учёные из Университета Рединга (Великобритания) выяснили, что на время трансатлантических перелётов влияют не только ежедневные погодные условия, но …

Томские ученые выяснили, как улучшить свойства ферритовых материалов для СВЧ-устройств Ученые Томского политехнического университета исследовали, как добавление редкоземельных элементов (РЗЭ) с разной... …

Ученые выяснили, что происходит с мозгом, когда слово «вертится на языке» Каждый сталкивался с такой ситуацией, когда в разговоре трудно вспомнить какое-то слово, имя или название. В это время создается ощущение, что нужная …

Железо животного происхождения повышает риск диабета, выяснили ученые Ученые из Гарвардской школы общественного здравоохранения имени Т.Х. Чана обнаружили связь между потреблением железа животного происхождения и повыше …

Длительное общение с ИИ может привести к психическим расстройствам, выяснили учёные Рост популярности ИИ-чат-ботов, которых пользователи выбирают в качестве собеседников для общения на разные темы, вызывает обеспокоенность психиатров …

Ученые выяснили, что окаменелые детские мумии Горини были младенцами Европейские исследователи установили, что все известные окаменелые детские мумии из коллекции XIX века, созданные итальянским экспериментатором Паоло …

Учёные выяснили, что пчёлы пережили палеоцен-эоценовый термический максимум Каждый день на планете идёт незаметный, но важнейший процесс — опыление. Насекомые, птицы и летучие мыши переносят пыльцу, даря жизнь плодам и семена …

Волны тепла угрожают жизни в Балтийском море, выяснили ученые Немецкие ученые из Института Лейбница изучили последствия тепловых волн в Балтийском море. Они пришли к выводу, что периоды сильной жары снижают уров …

Рождение магнетара: ученые выяснили, как появились эти удивительно плотные объекты Магнетар — это разновидность нейтронной звезды с удивительно мощным магнитным полем, которое может быть намного сильнее магнитного поля Земли. Интере …

Ученые выяснили, на какой день появляется результат во время голодания Исследования показали, что длительное голодание вызывает значительные и систематические изменения во многих органах тела. Результаты указывают на пот …

Учёные выяснили, как связано удаление волос в носу с развитием гипертонии У женщин в носу около 200 волос, у мужчин — 500-700, и риск болезни выше. Оказалось, что при удалении волос из носа — человек повышает ск …

Зверобой и не только: учёные выяснили, какие добавки помогают при депрессии Специалисты из Великобритании изучили несколько сотен клинических испытаний, в которых оценивалась эффективность 64 различных видов безрецептурных пи …

Учёные выяснили, какие продукты способны подавлять аллергию и воспаления Пищевая аллергия, вызванная гиперчувствительностью иммунной системы, поражает миллионы людей по всему миру. Среди наиболее распространённых аллергено …

Ученые выяснили, сколько новых звезд появляется во Вселенной каждую секунду Международная группа астрономов из США, Германии и Франции раскрыла механизм, с помощью которого газопылевые диски вокруг молодых звезд способствуют …

"Подземелья и драконы" помогают аутистам развить социальные навыки, выяснили ученые Настольная ролевая игра "Подземелья и драконы" (Dungeons and Dragons) может быть полезна для людей с расстройствами аутистического спектра (РАС), дав …

Красноярские ученые выяснили, как пожары и рубки нарушают микробные сообщества лесов Красноярские ученые выяснили, как пожары и рубки влияют на сообщества микроорганизмов в почве. …

Ядовитые птицы могут стать источником новых лекарств, выяснили ученые Немецкие ученые из Института фармацевтических исследований имени Гельмгольца обнаружили компоненты для новых лекарств в оперении тропической птицы Pa …

Уровень озона в Арктике достиг рекордно высокого показателя, выяснили ученые Американские ученые из Национального управления по аэронавтике и исследованию космического пространства (NASA) отметили рекордное восстановление озон …

Ученые выяснили: люди, которые делают ЭТО каждый день, живут на 7 лет дольше Революционные открытия долголетия Американская кардиологическая ассоциация представила обновленную концепцию «Основы жизни: 8 составляющих», которая …

В России ученые выяснили, как оценить уровень агрессии у подростков по движению глаз Российские ученые разработали подход, позволяющий оценивать склонность подростков к «внутренней» и «внешней» агрессии при помощи технологии айтрекинг …

Ученые выяснили, какая диета лучше всего подходит для пожилых людей Согласно новому исследованию, различные вегетарианские диеты, по-видимому, снижают риск смертности и связанных с ней заболеваний, при этом песко-веге …

Вызывают проблемы с сердцем, диабет и даже рак: ученые выяснили, чем опасны гирлянды С предупреждением выступили американские специалисты. Праздничные гирлянды могут навредить здоровью. Так считают ученые, которых цитируют американски …

К 2050 году мужчины будут чаще болеть раком, выяснили ученые Ученые из Университета Чарльза Дарвина в составе международного научного коллектива обнаружили, что к 2050 году среди мужчин в возрасте 65 лет и стар …

Летняя жара унесла десятки тысяч жизней европейцев, выяснили ученые Испанские ученые из Барселонского университета здравоохранения подсчитали количество летальных исходов в странах Европы из-за жары в 2023 году. Общее …

Мясо — не главное: ученые выяснили, что действительно влияет на рост мышечной массы Исследователи сосредоточились на трех ключевых вопросах: влияет ли тип белка на увеличение массы мышц, важно ли равномерное распределение потребления …

Люди с этой пагубной утренней привычкой обречены на бедность: это выяснили ученые Люди с этой пагубной утренней привычкой обречены на бедность: это выяснили ученыеРанний подъем как залог финансового успеха Экономисты и психологи вс …

Ученые выяснили, у каких людей риск рака крови снижен на треть Ученые из Венского университета и Тартуского университета установили, что редкий генетический вариант rs17834140-T замедляет распространение опасных …

Ученые выяснили, что роль молний в формировании жизни может быть преувеличена Ученые из Великобритании выяснили, что роль молний в формировании жизни на планете может быть преувеличена. Об этом сообщает Space. com. …

Дети-любимчики: ученые выяснили, кому достается больше родительской любви Между братьями и сёстрами существует особая связь, которая строится на общих воспоминаниях, семейных традициях и, конечно же, на спорах и противоречи …

Мужчины часто занижают возраст женщин при первом взгляде, выяснили ученые Первое впечатление о незнакомом человеке формируется за 7-10 секунд и уже на этом этапе искажается гендерными стереотипами — мужчины часто "занижают" …

Учёные выяснили, почему ваши наушники со временем теряют заряд батареи Вы когда-нибудь замечали, что ваши беспроводные наушники уже не держат заряд, как раньше? Группа исследователей из Техасского университета в Остине в …

Ученые выяснили, что ледяной покров Гренландии разрушается быстрее, чем когда-либо Исследование показало, что ледяной покров Гренландии, второй по величине в мире, разрушается быстрее, чем когда-либо прежде. Это вызвано изменением к …

Ученые выяснили, почему люди повторяют действия, даже когда это вредит Ученые из Технологического университета Сиднея установили, что компульсивное поведение может быть связано не с недостатком самоконтроля, а с его чрез …

Ученые выяснили, у кого риск смерти от рака мочевого пузыря повышен на 52% Нарушение цветового зрения может затруднять диагностику рака мочевого пузыря и повышать риск летального исхода заболевания на 52%. К такому выводу пр …

Ученые выяснили, что всего одна бессонная ночь может негативно повлиять на иммунитет Новое исследование продемонстрировало, что даже одна бессонная ночь способна существенно нарушить работу иммунной системы, увеличивая риск заболевани …

Ученые выяснили, как на самом деле эволюционировал мозг человека, опровергнув старые теории Исследование, опубликованное в журнале PNAS, перевернуло давние представления об эволюции человеческого мозга. Ученые из Университета Рединга, Оксфор …

Зомби-апокалипсис застыл в янтаре: ученые выяснили, что грибы порабощали насекомых еще при динозаврах Обнаруженные в бирманском янтаре окаменелости раскрыли любопытный факт: грибы, превращающие насекомых в послушных «зомби», существовали еще в эпоху д …

Учёные выяснили, что некоторые собаки способны учить новые слова, слушая разговоры Может ли собака выучить новое слово, если с ней вообще не разговаривают напрямую? Оказывается, да — по крайней мере, у небольшой группы "одарённых" п …

Перед сном читал – глупым стал: Учёные выяснили негативное влияние книг Электронные и бумажные книги имеют равное воздействие. Обычная привычка с чтением книг или просмотра телевизора перед сном мешает полноценному отдыху …

Ученые выяснили, что окружающая среда куда важнее генов в риске ранней смерти Исследования показали, что окружающая среда примерно в 10 раз важнее генов, когда речь идет о том, почему у некоторых людей риск ранней смерти выше, …

Крахмал в водорослях способен избавить планету от опасных парниковых газов, выяснили ученые Ученые из Университета Уппсалы обнаружили способ управлять накоплением крахмала в зеленых водорослях с помощью синего света. …

Ученые выяснили, смогут ли люди прокормиться дождевыми червями в случае ядерной войны Новозеландские, польские и американские ученые в сотрудничестве с некоммерческой организацией Alliance to Feed the Earth in Disasters установили, что …

Новые авиалайнеры ускоряют глобальное потепление сильнее старых самолетов, выяснили ученые Международная группа ученых из Великобритании и Германии выяснила, что новые авиалайнеры с более экологичными и экономичными двигателями парадоксальн …

Лёжа на правом боку: учёные выяснили, в какой позе таблетки усваиваются быстрее всего Задумывались ли вы, как положение тела во время проглатывания таблетки влияет на то, насколько быстро она подействует? Специалисты из Университета Дж …

Жир наносит ответный удар // Ученые выяснили, как быстро восстанавливается вес после отмены препаратов для похудения Зарубежные эксперты, проанализировав данные более 9 тыс. человек, выяснили, что после прекращения использования препаратов для похудения (включая «Оз …

При низких значения гемоглобина можно заподозрить анемию, рак и воспаление кишечника Кандидат медицинских наук Андрей Кондрахин призвал не игнорировать сниженные показатели гемоглобина. Причиной могут крыться в проблемах с ЖКТ или онк …

С утра опрокинул кружечку — и весь день бодрячком: ученые выяснили, какие утренние напитки гарантируют заряд позитива Немецкие ученые выяснили: первая чашка кофе или чая после сна – это не только ритуал, а импульс для позитива. Исследование с привлечением свыше 230 м …

Ученые выяснили, что газированная вода так же полезна для организма, как вода без газа Ученые сравнили негазированную фильтрованную воду с газированной фильтрованной. Хотя такие напитки, как содовая, минеральная, тоник и ароматизированн …

Генетики уточнили происхождение ямников Палеогенетики проанализировали больше 400 геномов древних людей, чтобы выяснить, как сформировалась популяция, оставившая после себя ямную археологич …

Подтверждено происхождение «инопланетных сигналов» Ученые из Китая вместе с иностранными коллегами благодаря китайскому радиотелескопу Five-hundred-meter Aperture Spherical Telescope (FAST) подтвердил …

«Происхождение вкусов: Как любовь к еде сделала нас людьми» Когда ученые обсуждают питание наших предков, речь чаще всего идет о выживании и почти никогда — об удовольствии. В книге «Происхождение вкусов: Как …

Радиотелескоп FAST выявил происхождение радиовспышек из космоса Ученые с помощью крупнейшего в мире радиотелескопа FAST, расположенного в Китае, получили доказательства гипотезы о том, что быстрые радиовсплески (F …

Стало известно происхождение фингала Илона Маска Американский бизнесмен Илон Маск и министр финансов США Скотт Бессент устроили драку в Белом доме в середине апреля 2025 года. Об этом сообщает газет …

Глава Роспотребнадзора не подтвердила лабораторное происхождение COVID-19 Глава Роспотребнадзора Анна Попова заявила, что доказательств лабораторного происхождения COVID-19 не существует. Заявление она сделала в связи с пуб …

Генетический анализ опроверг лабораторное происхождение COVID-19 Вирусолог Ши Чжэнли, фигурантка теории о лабораторном происхождении COVID-19, представила данные, подтверждающие отсутствие в её лаборатории образцов …

Минпромторг подтвердил российское происхождение коммутаторов «Ростелекома» Дочерняя компания «Ростелекома» — «НПО РТТ» — получила статус российского происхождения для двух линеек собственных Ethernet-коммутаторов: агрегации …

Каждый десятый житель Чехии имеет иностранное происхождение На конец 2024 года в Чехии проживало 10,8 млн человек, из которых 1,094 млн — иностранного происхождения, говорится в ежеквартальном отчете МВД Чехии …

Происхождение древних греков перестало быть научной тайной Часто ли вы задумывались о том, чем именно уникально греческое ДНК? Несмотря на повседневные сложности, которые порой ставят под сомнение психическое …

Утечка из лаборатории: Белый дом раскрыл истинное происхождение COVID-19 Истинная причина пандемии COVID-19 — утечка вируса из лаборатории в городе Ухань в Китае. Эта информация появилась на сайте Белого дома. В публ …

Расследование Конгресса показало лабораторное происхождение коронавируса SARS-CoV-2 Группа американских конгрессменов представила доклад, в котором содержатся результаты двухлетнего расследования происхождения коронавируса SARS-CoV-2 …

У оксфордской чаши из человеческого черепа выявили карибское происхождение Британский исследователь Дэн Хикс (Dan Hicks) из Музея Питт-Риверса изучил украшенную чашу из распиленного и хорошо обработанного человеческого череп …

Загадочная нейросеть Sonoma Sky Alpha превосходит GPT-5, но ее происхождение неизвестно Убийца GPT-5? Новая модель Sonoma Sky Alpha с контекстом в 2 млн токенов появилась на OpenRouter, и все указывает на то, что это Grok 4.2 от xAI Илон …

Коронавирус, вероятнее всего, имеет лабораторное происхождение и распространился из-за утечки Об этом стало известно после двухлетного расследования, результаты которого опубликовали американские конгрессмены. Отмечается, что вирус обладает би …

Новая теория предполагает происхождение тёмной материи до Большого взрыва Группа исследователей из Техасского университета в Остине (UT Austin) предложила новую модель, которая может изменить современные теории о происхожде …

Исследователи ВШЭ научили нейросети различать происхождение из генетически близких популяций В Институте искусственного интеллекта и цифровых наук ФКН НИУ ВШЭ предложили новый подход, основанный на современных... …

Глава Октябрьского района Волгограда объяснил происхождение плит на свалке Андрей Клыков, глава Октябрьского района Волгограда, опроверг информацию о том, что обнаруженные на свалке в Дзержинском районе мраморные плиты с име …

Происхождение нуждается в подтверждении // Как ТПП будет доказывать место производства иностранных товаров Торгово-промышленная палата может получить право верифицировать иностранные товары. Наделить ее таким правом просят импортеры, у них возникли проблем …

Тайна рождения золота раскрыта: редкий звёздный процесс объяснил происхождение драгоценностей Золото — один из самых ценных металлов на Земле, но его происхождение до сих пор оставалось загадкой. Американские физики из Университета Теннесси вп …

Кухня как центр современного дома Кухня давно перестала быть просто местом для приготовления пищи. Сегодня это пространство, где объединяются готовка, общение и повседневный комфорт — …

Компании из Китая начали скрывать происхождение товаров и обходить пошлины США через третьи страны Китайские компании активно используют схемы переадресации экспорта через третьи страны для обхода высоких таможенных пошлин, введенных администрацией …

Происхождение изменчивости рентгеновских фотонов от симбиотической двойной звезды, выявленное путем редукции размерности Симбиотические двойные звезды — это тип двойной звездной системы, которая состоит из компактной звезды (например, белого карлика) и красного гиганта. …

Продажи современного искусства выросли на 140 млн рублей В этом году, по данным ярмарки современного искусства «Арт Россия», продажи экспонатов достигли суммы 200 млн руб. Этот показатель вырос на 140 млн р …

Стала известна стоимость современного аналога Ан-2 Стоимость самолета «Байкал» (ЛМС-901), который позиционируют как аналог Ан-2, составляет 455 млн рублей. Об этом пишет РБК со ссылкой на письмо ГТЛК. …

Как изменились привычки современного автомобилиста в РФ – исследование Экосистема Сбера для автолюбителей провела исследование, чтобы составить портрет современного водителя и понять, какие сервисы и привычки помогают ем …

Оборудование для ресторанов — что выбрать для современного ресторана Правильно подобранное оборудование помогает рестораторам достичь высоких стандартов сервиса и удовлетворить ожидания клиентов. …

В Курске открылся музей современного искусства - В основном все мои картины находятся в Австрии, - говорит Игорь Торшенко. – Я подумал: ну что же все за границей. Поэтому специально привез работы. …

На Сахалине презентовали создание современного Экополиса Здесь планируется построить новый благоустроенный район с социальными объектами и рабочими местами для квалифицированных специалистов …

Базовым станциям расставят оценки // Российское происхождение телеком-оборудования будет подтверждаться по балльной системе Минпромторг предложил оценивать степень импортозамещения для телеком-оборудования (базовых станций связи и т. д.) с помощью балльной системы, наравне …

В Тверской области сотрудник ГИБДД не смог пояснить происхождение десятков миллионов рублей на банковских счетах Органы прокуратуры провели проверку соблюдения законодательства о противодействии коррупции в УГИБДД УМВД России по Тверской области и установила, чт …

«Пыль. История современного мира в триллионе пылинок» Пыль чаще всего состоит из частиц от 1 до 10 микрометров — для сравнения, средний диаметр человеческого волоса составляет от 70 до 90 микрометров. Не …

Милонов назвал главную «болезнь» современного кино Депутат Госдумы Виталий Милонов выразил мнение, что ключевой недостаток современных кинолент и телевизионных программ заключается в навязывании идеи …

В Петербурге прошёл фестиваль современного танца OPEN LOOK Как всегда, программа фестиваля вместила в себя как работы основоположников современного танца нашей страны, так и самую молодую генерацию хореографо …

В Петербурге открылась выставка современного искусства с Дона Выставка стала четвертой в большом цикле "Открытый мир", который Музей Фаберже посвятили 80-летию Победы и искусству российских регионов. После Урала …

Почему «прикуривание» превратилось в лотерею для современного авто Попытка «прикурить» севший аккумулятор от другой машины – казалось бы, проверенный годами способ оживить автомобиль зимой. Однако для современных авт …

В Музее современного искусства ЕАО открылась выставка дальневосточных художников Межрегиональная выставка «Традиция» открылась в Музее современного искусства ЕАО. Автор проекта, Алексей Авдеев, председатель Хабаровского краевого о …

Медучреждения Ставрополья получили более 740 единиц современного оборудования В Министерстве здравоохранения Ставропольского края рассказали, что медучреждения региона получили более 740 единиц современного оборудования. …

В Стародубе близится к финалу строительство современного спорткомплекса с бассейном Объект готов на 90%. В Стародубе продолжают возводить спортивно-оздоровительный комплекс. Уже установлены каркасы перегородок, смонтирована электропр …

Жуткие дорожные заторы в СССР глазами современного автомобилиста Сразу отвечу на вопрос: пробки в СССР были! Можно считать это одним из парадоксов социализма: автомобилей, по нынешним понятиям, практически не было, …

Они не остановятся, значит, мы должны их остановить. Немного о жестокости современного мира Геополитическая ситуация в мире изменилась коренным образом. Достигнуть компромисса путем переговоров уже не получится. Нужны более радикальные меры, …

Третьяковская галерея приняла решение о закрытии секции современного искусства В ходе организационных преобразований в Третьяковской галерее, Отдел новейших течений будет объединен с Отделом искусства второй половины ХХ-ХХI века …

В Курской областной Думе обсудили духовные ориентиры современного общества В областной Думе собрались депутаты, представители церкви, общественных и молодёжных организаций, педагоги, ветераны и участники СВО. В этом году они …

Телеведущий-натуралист Баженов поддержал создание современного цирка в Москве Телеведущий, известный своими передачами о природе и животных, а также депутат Госдумы РФ и общественный деятель Тимофей Баженов поделился с РИА Ново …

8 периодов в истории нашей планеты, когда её вид кардинально отличался от современного Джунгли на полюсах, розовые моря, свободные от насилия подводные сады и миллиард лет прокрастинации. …

Авианосец современного искусства // Fondation Cartier обрел новый дом в Париже Фонд современного искусства Cartier открыл 25 октября новое здание возле Лувра: архитектор Жан Нувель создал настоящую музейную машину, спрятанную в …

Одиночество – болезнь современного человека: от депрессии помогут спасти объятия Доктор Софья Сулим прокомментировала появившуюся в Китае услугу, где мужчины обнимают девушек за деньги, пишет «Москва 24». К такому феномену приводи …

Павел Дуров посетил выставку современного искусства Art Dubai 2024 Российский бизнесмен, основатель соцсети "ВКонтакте" и мессенджера Telegram Павел Дурова посетил выставку-ярмарку современного искусства в Дубае Art …

В районе Северный выделен участок для строительства современного фармацевтического предприятия Его строительство позволит оптимизировать логистику поставок препаратов и обеспечить их стабильное наличие в аптеках и других медицинских учреждениях …

Автомобильные концерны отстают от Tesla и китайских конкурентов в разработке современного ПО Глобальные автомобильные концерны от Toyota и Volkswagen до General Motors всё больше отстают от Tesla и китайских конкурентов в разработке критическ …

В городе Зарайск с 23 ноября стартует фестиваль современного искусства «Перезагрузка. 2.0» Фестиваль «Перезагрузка. 2.0» посвящен современному искусству и включает культурные и образовательные программы. Основной площадкой станет обновленно …

«Однофамилец» современного танка — почему у него такая странная форма? 80 лет Великой Победе! В этом году мы отмечаем 80-летие Победы, завоеванной благодаря мужеству народов СССР – десятков миллионов людей! Редакция «За …

Иллюзия превращений – выставочный проект объединил художников современного искусства Новый мультидисциплинарнарный выставочный проект включает авторскую живопись, трехмерные скульптуры, лентикулярные картины, технологию виртуальной ре …

Более 300 единиц современного оборудования за 95,3 млн рублей получил краевой медцентр Ставрополья Краевой центр специализированных видов медицинской помощи получил универсальную систему ультразвуковой визуализации «РуСкан 65» стоимостью 8,38 млн р …

Международный союз современного пятиборья смягчил санкции в отношении российских спортсменов Федерация современного пятиборья России сообщила на сайте, что исполком Международного союза современного пятиборья (UIPM) частично снял ограничения …

В Центре современного искусства «Быль» проходит выставка художников по керамике и текстилю В экспозиции собраны работы, созданные по традиционным и экспериментальным технологиям лепки, обжига, изготовления глазурей, вязания и ткачества. …

Выставка известного художника Никаса Сафронова открылась в Музее современного искусства ЕАО Уникальная передвижная выставка художника Никаса Сафронова прибыла в Биробиджан. Музей современного искусства украсили более 100 работ известного тво …

В Cube.Moscow 21 декабря пройдет открытие восьми экспозиций современного искусства В арт-пространстве Cube.Moscow 21 декабря откроется новая выставка с произведениями молодых талантов из Московской школы современного искусства и тем …

В Театре МОСТ покажут спектакль по пьесе современного классика Эдварда Радзинского 26 августа, 23 сентября, 21 октября в 19:00 (мск) Театр "МОСТ" представит пьесу, которая более 60 лет стала популярной и с тех пор не отпускает внима …

«Фактически выставка получает триеннальный шаг» // Дмитрий Буткевич — о II Чувашской биеннале современного искусства Обозреватель “Ъ FM” Дмитрий Буткевич рассказывает, как изменилась концепция выставки с приходом нового куратора. …

На Васильевском острове начал работу Центр современного искусства имени Сергея Курехина Центр современного искусства имени Сергея Курехина начал свою работу на Васильевском острове. На нескольких тысячах квадратных метров расположились д …

В темноте, но не в обиде: в Art-Space эпатажно открылась выставка современного искусства «Эмоции в цвете» Выставка «Эмоции в цвете» открылась в московском Art-Space 16 января 2025 года. Событие, организованное Общественным Фондом поддержки культуры... …

В Центре современного искусства «Быль» пройдёт выставка работ в концепции русского авангарда Зрителям представят не только картины, но и работы в керамике, графике, дизайне одежды и причёсок, архитектуре, пэчворке, вышивке, свечном деле, макр …

Брянцам рассказали о Международной выставке-конкурсе современного искусства «Российская Неделя Искусств» С 6 по 15 декабря 2624 года в Москве пройдет XXXVI Международная выставка, ярмарка и конкурс современного искусства «Российская Неделя Искусств». Рос …

Жители Тверской области могут проявить себя в конкурсе современного плакатного искусства Жителей Верхневолжья в возрасте от десяти лет приглашают к участию во втором сезоне конкурса современного плакатного искусства имени Героя России Сер …

Фетисов — о включении Могильного в Зал славы: «Достойный член золотого пантеона современного хоккея» Двукратный олимпийский чемпион Вячеслав Фетисов в разговоре с «СЭ» отреагировал на включение экс-нападающего клубов НХЛ Александра Могильного в Зал х …

Двор художника и музыка на закате: в Самаре стартовал фестиваль городских практик и современного искусства В ожидании перемен Фестиваль проходит в Самаре в четвертый раз. Он посвящен новым способам взаимодействия с городским пространством и художественным …

В Музее современного искусства открылась выставка работ молодых художников по итогам выездной практики Выставка по итогам областного пленэра уходящего лета открылась в Музее современного искусства. Сам процесс создания картин начался на комплексе «Фома …

Жителей Брянской области приглашают принять участие в Конкурсе современного плакатного искусства «Время смыслов» Аппарат полномочного представителя Президента Российской Федерации в Дальневосточном федеральном округе проводит второй сезон Конкурса современного п …

«Смоленское Поозерье» получило мощный импульс для развития туристической отрасли с открытием современного визит-центра В ходе разработки концепции развития национального парка специалисты фонда «Заповедное посольство» провели социологическое исследование, которое легл …

Насколько сильно Huawei Mate 20 Pro (2018) отстаёт от современного Mate 70 Pro (2025) На YouTube-канале "ЧЕСТНЫЙ БЛОГ" рассказали, в чём конкретно за семь лет изменился Huawei Mate 70 Pro по сравнению с Mate 20 Pro. У Mate 20 Pro ещё н …

Организаторы фестиваля "Музыкальное сердце театра" объявили имена новых членов Академии современного музыкального театра Ксения Аитова - театральный критик, арт-директор международного конкурса новой драматургии "Ремарка", эксперт и член жюри театральных конкурсов. В 20 …

В ВТБ выяснили, чьи финансовые советы слушают россияне Больше половины опрошенных (53%) доверяют рекомендациям специалистов банка — для россиян это самый авторитетный источник информации при выборе финанс …

Исследователи НИУ ВШЭ выяснили, как нейросети понимают каламбуры Международная команда с участием исследователей ФКН НИУ ВШЭ представила KoWit-24 — корпус из 2700 русскоязычных заголовков... …

В Костроме выяснили, что скрывает горячий бортпроводник Напомним, сексуальный Даниил снялся в рекламе костромского ювелирного бренда. Харизма нового амбассадора «SOKOLOV»* покорила всех на съемоч …

Твердотельные накопители Digma Meta M6E, Meta P21 и Meta S69 емкостью 1 ТБ: твердый средний класс современного сегмента PCIe Gen4 на любой вкус Сегодняшняя тройка накопителей Digma Meta — типичные представители NVMe SSD современного среднего класса с поддержкой PCIe Gen4. Разве что предсказуе …

СМИ выяснили причину отсутствия Стармера на переговорах с Зеленским Британский премьер Кир Стармер пропустил важные субботние консультации с украинским президентом Владимиром Зеленским и руководителями ключевых европе …

ИИ развил в себе «инстинкт выживания», выяснили исследователи В прошлом месяце Palisade Research, занимающаяся исследованиями в сфере безопасности в сегменте искусственного интеллекта, поделилась результатами пр …

Эксперты выяснили, кто лучше разбирается в компьютерах и интернете Учёные из НАФИ изучили, насколько хорошо люди в России, Беларуси и Казахстане умеют искать информацию в интернете, создавать свой контент, общаться в …

Эксперты выяснили, что россияне знают о самозапрете на кредиты С 1 марта 2025 года в России начнет действовать механизм самозапрета на кредиты и займы, однако знают о такой возможности только 39% потребителей фин …

СМИ выяснили о желании ЦСКА продлить контракт с защитником команды По информации СМИ, в московском ЦСКА собираются продлить контракт с 20-летним центральным защитником Матвеем Лукиным. …

В CowCotLand выяснили, стоит ли владельцам RTX 3070 обновляться на RTX 5070 Французское издание CowCotLand провело сравнение видеокарт GeForce RTX 3070 и RTX 5070, чтобы определить, есть ли смысл обновляться. Тесты показали, …

Аналитики выяснили, какие подарки россияне покупают на Новый год Аналитики финтех-компании ЮMoney и ИТ-компании «Эвотор» проанализировали предновогодние покупки россиян с 1 по... …

Аналитики выяснили, сколько будет стоить букет ко Дню матери В преддверии Дня матери аналитики «АТОЛ Онлайн» провели исследование, посвященное ценам на цветы в России. Оно проводилось на основе обезличенных дан …

Какие автомобили подешевели в этом году, выяснили эксперты Эксперты банков ВТБ, «Открытие» и компании «Автомаркетолог» проанализировали динамику средневзвешенных цен на новые легковые машины в России и опреде …

Исследователи выяснили, что на самом деле способствует счастью человека Новое исследование, опубликованное в журнале PLOS One показывает, что для молодых одиноких людей в возрасте 18–24 лет дружба может быть ключевым факт …

Эксперты выяснили, что «китайцы» дешевеют не быстрее других машин Группа «Ренессанс Страхование» и Pango Cars провели исследование, в котором изучили изменение стоимости подержанных автомобилей китайских марок по от …

Луна возникла практически одновременно с Землей, выяснили планетологи Американские и европейские планетологи проанализировали состав древнейших горных пород Луны и пришли к выводу, что она возникла значительно раньше, ч …

Исследователи выяснили, что музыка ускоряет восстановление после операции Учёные выяснили, что музыка оказывает позитивное воздействие в постоперационный период: снижает частоту сердечных сокращений, уровень тревожности и о …

СМИ выяснили, в каком случае Зеленский пойдет на уступки по территориям Члены Еврокомиссии (ЕК) считают, что президент Украины Владимир Зеленский пойдет на территориальные уступки в рамках урегулирования конфликта в случа …

Аналитики выяснили, как российский бизнес адаптируется к пиковым нагрузкам В осенний период увеличивается деловая активность и объем коммуникации на всех управленческих уровнях, растет число отраслевых и корпоративных конфер …

СМИ выяснили, в каком случае Зеленский пойдет на территориальные уступки Члены Еврокомиссии считают, что президент Украины Владимир Зеленский пойдет на территориальные уступки в рамках урегулирования конфликта с Россией в …

СМИ выяснили, кто мог заблокировать решение Мерца по поставкам Taurus Киеву Министр финансов ФРГ Ларс Клингбайль, представляющий социал-демократов, мог заблокировать отправку дальнобойных ракет Taurus Украине, которые ранее б …

Аналитики выяснили, где в России быстрее всего накопить на частный дом Специалисты компании "Мир квартир" провели исследование и определили регионы России, где можно быстрее всего накопить на покупку собственного дома пр …

«Ростелеком» и «Леста Игры» выяснили, чем займутся геймеры на праздниках Геймеры активнее других жителей страны строят планы на предстоящие праздники: они планируют путешествовать... …

Исследователи выяснили сколько россияне готовы тратить на образование Россияне готовы тратить 24% дохода на онлайн-курсы, выяснила платформа GetCourse. В регионах 32% готовы платить за обучение более 15 тыс. руб. …

Диетологи выяснили самый полезный способ приготовления гречки Она вкуснее, сохраняет больше витаминов и проще усваивается в организме. 99% россиянок предпочитают варить гречку, но пользы от этого мало. Диетологи …

Врачи выяснили, при какой температуре развивается смертельный вирус Отличить пневмонию от простуды сможет каждый. Всех въезжающих в страну из-за границы уже проверяют термометрами. Простой метод можно использовать и д …

СМИ выяснили сумму премиальных игрокам "Зенита" за победу над "Краснодаром" По информации СМИ, в случае победы над "Краснодаром" в матче 24 тура РПЛ премиальные каждому игроку петербургского "Зенита" составят 110 тысяч евро. …

Исследователи выяснили, как разные поколения относятся к влиянию ИИ на карьеру 80% работников уверены, что ИИ повлияет на их рабочие задачи. Поколение Z волнуется больше всего. Спрос на навыки работы с ИИ-агентами вырос на 1587% …

Какой популярный завтрак мешает похудеть, выяснили диетологи В кукурузных хлопьях содержится меньше 2% злаков. Учёные из Стэнфорда выяснили что, после тарелки сухих завтраков с молоком, днём происходят резкие с …

Аналитики выяснили, что мужчинам нужно для счастья больше денег, чем женщинам В Перми был проведён опрос, в ходе которого местные отвечали, сколько денежных средств им нужно для полного счастья. Согласно результатам сбора данны …

Эстонские власти выяснили, что упавший на территории страны дрон был украинским В Эстонии получили результаты расследования, связанного с инцидентом, когда в августе этого года рядом с российской границей был обнаружен разбившийс …

В Anthropic выяснили, что делает ИИ злым и научились пресекать вредные паттерны Компания Anthropic представила исследование, посвящённое тому, как у искусственного интеллекта формируются стиль ответов, тон и общая направленность …

Эксперты выяснили, какими мессенджерами чаще всего пользуются мошенники Самым популярным мессенджером среди злоумышленников является Viber.Об этом заявил доктор юридических наук, профессор, заслуженный юрист России Иван С …

ИИ-боты выяснили, кто из них лучше всех играет в «Мафию» — не обошлось без странностей Разработчик под псевдонимом Guzus создал сайт, на котором большие языковые модели искусственного интеллекта получили возможность сыграть в классическ …

Популярный китайский седан на замену Camry: выяснили, насколько он надежен В Китае седан Chery Arrizo 8 производится с 2022 года, у нас появился годом позже. Его платформа M1X – легковая версия кроссоверной T1Х, на которой б …

Журналисты выяснили, когда выйдет четвёртый сезон «Ведьмака» от Netflix Фэнтезийный сериал «Ведьмак» (The Witcher) от стримингового гиганта Netflix готовится к старту четвёртого сезона до конца 2025 года, одна …

Эксперты выяснили, насколько безопасен этот популярный недорогой «кореец» Организация LatinNCAP, выступающая аналогом европейского EuroNCAP для Латинской Америки, проверила безопасность популярного в России корейского седан …

СМИ выяснили, сколько смогут заработать Фоменко и Леонидов на группе «Секрет» Николай Фоменко и Максим Леонидов, несмотря на то что живут в разных странах, продолжают совместную работу над новыми композициями группы «Секрет» …

Геологи выяснили под каким углом упал астероид, уничтоживший динозавров При помощи моделирования они воспроизвели события, произошедшие 66 миллионов лет назад. Британские учёные воссоздали трехмерную форму кратера, считаю …

Аналитики выяснили, сколько россиян планируют подрабатывать в 2026 году Аналитики сервисов «Работа.ру» и «Подработка» провели исследование и узнали планы россиян на подработку в 2026-м. RT ознакомился с результатами. …

Песков: Наши спецслужбы уже выяснили, кто заказал убийство генерала Кириллова Российские спецслужбы и правоохранительные органы работают эффективно, расследуя убийство начальника войск РХБЗ Игоря Кириллова. Об этом сегодня, 18 …

Геологи выяснили, что катастрофа Аральского моря влияет на недра Земли Новое исследование, опубликованное в журнале Nature Geoscience, показало, что Земля под бывшим Аральским морем продолжает подниматься, несмотря на пр …

Эксперты выяснили, когда у россиян появляются деньги на первый автомобиль Согласно опросу компании «Сберстрахование», 41% россиян приобретают свой первый автомобиль до 25 лет; 19% - в возрасте от 26 до 30 лет, а чуть больше …

В выходные чаще посещают салоны красоты, выяснили эксперты федерального банка Наибольшее количество оплат в парикмахерских и салонах красоты было зафиксировано в феврале в Москве, однако средний чек оказался выше на Кавказе. …

В Авито Услугах выяснили, какие услуги по обучению в сфере IT востребованы у россиян По данным Авито Услуг, в 2024 году спрос на услуги специалистов по обучению IT-специальностям в целом увеличился в России наполовину (+56%) по сравне …

Блогеры выяснили, кто быстрее, Bugatti Chiron Super Sport или Rimac Nevera Заезды прошли на взлетной полосе Космического центра Кеннеди в США. За рулем обеих машин сидели заводские тест-пилоты Rimac и Bugatti. Гиперкарам пре …

Аналитики Blink выяснили, какие смартфоны и операторов выбирает российская молодёжь Аналитики приложения Blink подвели итоги 2025 года и выяснили, какими смартфонами и мобильными операторами чаще всего пользуются молодые россияне. Ис …

Магнитные наночастицы могут помочь в борьбе с клетками опухоли, выяснили в России Ученые Сибирского государственного медицинского университета (СибГМУ) исследовали, как магнитные наночастицы проникают в опухолевую ткань и с какими …

Эксперты выяснили, что средний чек на пляжный отдых в России достиг 57 тысяч рублей Согласно данным Российской Ассоциации туроператоров (АТОР), при предварительном бронировании туров в 2025 году средний расход на поездку составляет 5 …

Правоохранители выяснили, что супруга экс-главы КРКО владеет BMW X6 с элитным номером в 10 млн рублей Автомобиль BMW X6 2020 года выпуска с красивым номером оформлен на жену экс-главы КРКО Владимира Лукина, который обвиняется в злоупотреблении должнос …

Следователи выяснили детали зверского убийства российской модели и ее дочери бывшим мужем В конце ноября 2023 года на обочине дороги в Бодруме нашли тела россиянки и ее 15-летней дочери. Подозреваемого в убийстве установили сразу, но рассл …

В Омской области выяснили, сколько людей живут на зарплату ниже прожиточного минимума Прожиточный минимум в регионе составил 16 816 рублей, но минимальные зарплаты для бюджетников и коммерческих работников значительно выше. …

Турецкие следователи выяснили детали зверского убийства россиянки Двизовой бывшим мужем Турецкие следователи установили, что Андрей Кушлевич, обвиняемый в убийстве своей бывшей супруги Ирины Двизовой и её 15-летней дочери Даяны, не имел …

Диетологи выяснили, какую новую кашу надо добавить в рацион питания для иммунитета 100 г киноа в день заменят горсть лекарств для костей и сердца. Ценность каши заключается в уникальности состава, который способен воздействовать на …

Популярный оператор и отец двоих детей: в сети выяснили, с кем встречается Кристина Асмус В сети раскрыли личность нового возлюбленного 37-летней Кристины Асмус — им, предположительно, оказался 41-летний Валерий Махмудов. Расследование про …

Уволенный Путиным экс-глава Минтранса Старовойт покончил с собой. СМИ выяснили подробности трагедии Отправленный в отставку министр транспорта найден мертвым. Раскрыто, что он написал в предсмертном сообщении. …

Данные тысяч ставших частными репозиториев GitHub всё ещё доступны в Copilot, выяснили исследователи Согласно исследованию израильской компании по кибербезопасности Lasso, специализирующейся на возникающих угрозах генеративного ИИ, данные, которые бы …

Журналисты выяснили, кто снимет и напишет фильм по Call of Duty — режиссёр «Хэнкока» и соавтор «Йеллоустона» Анонсированная в прошлом месяце кинокомпанией Paramount официальная экранизация популярной серии военных шутеров Call of Duty от Activision обрела ре …

После замечания Путина СМИ выяснили, сколько раз Набиуллина посещала заседания кабмина в этом году Председатель Центрального банка России Эльвира Набиуллина очень редко присутствует на заседаниях правительства, и на это обратил внимание глава госуд …

Исследователи выяснили, как семь планет системы TRAPPIST-1 приобрели свои уникальные орбитальные резонансы Учёные, возможно, наконец-то раскрыли историю системы TRAPPIST-1, сложного набора из семи планет, которые находятся примерно в 40 световых годах от н …

Выщипал брови – состарил годы: Врачи выяснили, почему обычный тренд красоты опасен Слёзы от боли ускоряют появление морщин под глазами. Многие женщины считают тонкую бровь каноном красоты. Но мало кто знает, что от ширины брови зави …

В США уходит вдвое больше времени и денег на строительство фабрики чипов, чем на Тайване, выяснили аналитики Строительство современных предприятий по производству чипов требует миллиардов долларов капитальных затрат. В среднем на одну крупную фабрику необход …

Недвижимость на 3 млрд рублей: в сети выяснили финансовое состояние семьи 19-летней невесты Григория Лепса В сети вновь обсуждают финансовое состояние семьи 19-летней невесты Григория Лепса. В результате расследования, которое провёл телеграм-канал Shot, в …

Дружи, пока молодой // Социологи выяснили, что в странах БРИКС думают об этой организации и друг о друге Молодые люди из ключевых стран БРИКС заинтересованы в развитии объединения, следует из результатов социологического исследования (есть у “Ъ”), провед …

Миллиардер и аристократ: в сети выяснили личность мужа любовницы главы Astronomer, которых засняли вместе на концерте Coldplay В сети продолжают обсуждать измену гендиректора IT-компании Astronomer Энди Байрона, которого засняли на концерте Coldplay в обнимку со своей сотрудн …

Возвращение муравьиных львов, полноценная баллистика и подготовка к релизу: датамайнеры выяснили новые подробности разработки Half-Life 3 Датамайнеры Максим Полетаев (он же Gabe Follower) и Тайлер Маквикер (Tyler McVicker) поделились новыми находками в отношении разработки секретной игр …

Эксперты выяснили, как частота работы ОЗУ DDR5 влияет на производительность процессоров Ryzen 7 7800X3D, 7 7700X, Core i7-14700K и i7-12700K в играх Актуальные процессоры Ryzen 7 7800X3D и Ryzen 7 7700X проверили с оперативной памятью DDR5-5200 CL40 и DDR5-6000 CL30. Современный чип Intel Core i7- …

Вырезанный контент, бесшовный мир и никаких «современных» эпизодов: журналисты выяснили новые детали ремейка Assassin’s Creed IV: Black Flag Журналисты французского издания Jeux Vidéo Magazine со ссылкой на источники внутри Ubisoft поделились новыми подробностями до сих пор не анонс …

От iPhone 12 Pro Max до iPhone 17 Pro Max: выяснили какой смартфон Apple быстрее всех работает в 2025 Выясняем, как изменилась скорость работы iPhone за 5 лет. Фото: 9to5mac Ежегодно Apple заявляет, что новый iPhone становится мощнее и быстрее предыду …

В Gizmochina выяснили, имеет ли смысл менять iPhone SE 3 на iPhone 16e iPhone SE 3-го поколения остается популярным вариантом для тех, кто ищет недорогой смартфон, тогда как iPhone 16e предлагает современную начинку, одн …

Учёные победили деменцию Прорывной препарат, который останавливает развитие болезни на ранних стадиях, создали в Австралии. Он стабилизирует клетки мозга и предотвращает их п …

Российские учёные усовершенствовали MP3 Российские учёные из Московского технического университета связи и информатики (МТУСИ) усовершенствовали алгоритм сжатия звука MP3 — его новый вариан …

Учёные о квадробинге: это не болезнь Академик РАН Геннадий Онищенко заявил, что квадробинг не является психическим заболеванием. Он считает, что это просто модное явление, которое активн …

Российские ученые удешевили производство шин В пресс-службе Воронежского государственного университета инженерных технологий (ВГУИТ) сообщили, что ученые вуза запатентовали новый способ выделени …

Ученые нашли объяснение прокрастинации Ученые из Университета Киото изучили работу мозга макак и обнаружили своеобразный «тормоз мотивации», который может отвечать за прокрастинацию — скло …

Как ученые поняли, что курение вызывает рак По данным ВОЗ, причиной рака легких в 85% случаев является курение сигарет. Источник изображения: stock.adobe.com Сегодня в это трудно поверить, но к …

Учёные объединили квантовую химию и ИИ Катализаторы — основа современной промышленности: они участвуют в производстве более 80% товаров, от лекарств до пластмасс. Особенно важны переходные …

Ученые выявили то, что вызывает рак на кухне Шокирующие результаты исследования опубликовали британские ученые. Они изучили кухонные принадлежности, используемые в быту. Оказалось, что кухонная …

Ученые изучили окаменевший кал динозавров Ученые получили ценные сведения о рационе динозавров, изучив копролиты — окаменевшие фекалии, образовавшиеся миллионы лет назад. Недавняя находка в П …

Ученые развеяли «миф с бородой» об аспирине Десятилетия врачи рекомендовали здоровым пожилым людям принимать низкие дозы аспирина ежедневно для профилактики сердечных приступов. Однако в 2019 г …

Ученые обнаружили «темный кислород», ... Международная группа ученых обнаружила, что кислород вырабатывается картофелевидными металлическими конкрециями на глубине тысячи футов под поверхнос …

Учёные: «Смартфоны вызывают ожирение» Эксперты дали советы по правильному использованию гаджетов. Венесуэльские ученые провели масштабные исследования, в ходе которых пришли к печальным р …

Вторую Землю нашли учёные Астрономы выяснили, что существует "вторая Земля", которая, возможно, состоит из свинца. Эта планета немного больше нашей. Однако она почти в 8 раз т …

Ученые улучшили свойства пива Российские и новозеландские ученые придумали, как обогатить пиво полезными веществами. В популярный напиток они ввели экстракт микроводорослей, что у …

Учёные создали препарат от ВИЧ с 99%-й эффективностью Это инъекция, называется «Ленакапавир». Она выигрывает не только по эффективности, но и простоте использования. До этого исследователи провели испыта …

Ученые разобрали мифы о метеозависимости Специалисты объяснили, что на самом деле стоит за понятием «метеозависимость», которое часто используют для объяснения плохого самочувств …

Ученые: имя влияет на внешность человека Ученые убеждены: имя и ассоциации с ним накладывают особый отпечаток на внешность и характер человека. Они провели специальный эксперимент: попросили …

Ученые предупредили о катастрофе на Земле Согласно исследованию ученых из канадского Университета Макгилла, продолжающиеся выбросы парниковых газов и вызванное этим повышение уровня Мирового …

Учёные разрушили миф о вечной жизни Медицинские достижения заметно увеличили продолжительность жизни в богатых странах, но ожидания о долгой жизни до 150 лет — слишком оптимистичны. Исс …

Ученые получили изображение экзопланеты AF Lep b Американские ученые решили запечатлеть экзопланету AF Зайца b до того, как она максимально приблизится к звезде-хозяину. После этого планету будет не …

Учёные создали препарат, защищающий от ВИЧ Лекарство прошло последнюю стадию испытаний. В случае одобрения американским Минздравом продажи могут начаться уже в 2025 году. Препарат получил край …

Учёные научились лечить синдром Дауна Японские исследователи смогли полностью устранить 47-ю хромосому. Они модифицировали ДНК и убрали лишние участки. Это привело к тому, что гены, нервн …

Ученые нашли «выключатель страха» в мозгу Исследователи из Калифорнийского университа провели масштабное исследование механизмов подавления х страхов, возникающих у животных на уровне инстинк …

Омские учёные выходят на финишную прямую Введение санкций и потребность импортозамещения привело к высокому спросу на отечественные инновации. …

Как учёные помогают «видеть» беспилотным автомобилям? Беспилотные автомобили — это уже не фантастика, а реальность, которая постепенно воплощается в жизнь. Но тема это довольно новая и не такая развитая, …

Мир не трехмерен, ученые сделали сенсационное открытие Физика столкнулась с одной из самых ошеломляющих загадок в своей истории: новая гипотеза переворачивает привычные представления о времени и пространс …

Учёные спрогнозировали формирование суперконтинента через 250 млн лет Представьте себе мир, где жара убивает быстрее, чем болезни, а океанские бризы исчезают с лица планеты. Такой сценарий не фантастика, а вполне реальн …

Ученые обнаружили на Курилах редкий вид песцов Фонд «Природа и люди» провел на Курильских островах экспедицию по наблюдению за редким подвидом голубого песца -- медновского. Ученые находились на о …

Ученые РТУ МИРЭА разработали нанокомпозиты для сенсоров В пресс-службе РТУ МИРЭА сообщили, что специалисты вуза разработали новый метод управления оптическими свойствами нанокомпозитов. Речь идет о материа …

Мышь-мамонта вывели учёные из США: как она выглядит? Биотехнологическая компания из США вывела необычное существо — мышь-мамонта. У этого животного даже есть некоторые черты, которые похожи на шерстисто …

Китайские ученые зафиксировали рост Эвереста Высота горы Эверест постоянно увеличивается. К такому выводу пришли ученые Китайского геологического университета в Пекине. …

Российские ученые ускорили обучение нейросетей В пресс-службе Высшей школы экономики сообщили, что специалисты вуза разработали подход, который повышает эффективность обучения генеративных потоков …

Сахалинские ученые создали батарейки из водорослей В пресс-службе Сахалинского государственного университета сообщили, что ученые вуза разрабатывают новый тип литий-ионных аккумуляторов с использовани …

Учёные обнаружили особые РНК, защищающие ВИЧ от иммунитета Исследователи ВИЧ обнаружили новый механизм, с помощью которого вирус обходит иммунную систему и использует ресурсы хозяина. Исследование опубликован …

Ученые создали мозговой чип для чтения мыслей Фото: Stanford Medicine По результатам исследований, точность считывания составила 74%. Ученые из Стэнфордского университета представили результаты и …

Ученые обнаружили новый вид опасных червей Международная группа исследователей из Национального музея естественной истории, а также университетов Дрекселя, Северной Каролины, Джеймса Кука и Ще …

Как выбрать спутника жизни, рассказали учёные из США Учёные из Бингемтонского университета провели исследование семейных отношений. Они задались вопросом повальной причины разводов и пришли к мнению, чт …

Новосибирские ученые создали вегетарианский гематоген Специалисты Новосибирского государственного аграрного университета разработали уникальную рецептуру гематогена для вегетарианцев. В традиционной реце …

Ученые УГНТУ сделали новое открытие По аналогии с процессом фотосинтеза у растений, микроводоросли способны поглощать углекислый газ и выделять кислород. Но делают они это в несколько с …